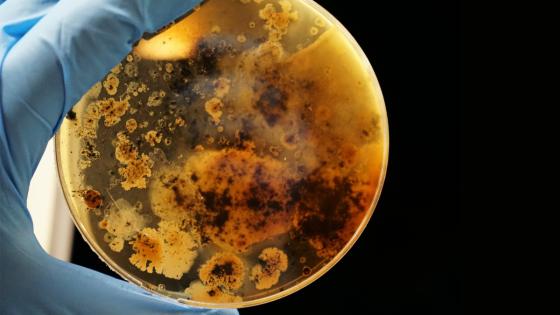

Las personas utilizan antibióticos por diferentes motivos, entre ellos contrarrestar las infecciones causadas por las bacterias, pero aprovechando la 'Semana Mundial de Concientización sobre el Uso de Antibióticos', la Organización Mundial de la Salud (OMS) afirmó la seria amenaza que podrían ser los medicamentos antimicrobianos y antibacterianos a la salud pública.
Las bacterias que se encuentran en los animales pueden causar graves afectaciones en los seres humanos, según la OMS en algunos países el 80% del total de consumo de antibióticos médicamente importantes se utilizan solo en el sector animal.
- Lea también: ¿Cómo ayudar a los animales afectados por el huracán Iota?
- Además: Aprobado en primer debate el proyecto de ley para crear cédula animal
“Sí, los antibióticos son utilizados en los animales con tres fines. El primero como promotor de crecimiento este es opcional, es decir no todos los animales de granja reciben medicamentos como promotor de crecimiento pero sí sabemos que hay un uso de este tipo de medicamentos para ese fin. El segundo objetivo es prevenir enfermedades como los animales están hacinados en granjas y sin la posibilidad de tener un mayor distanciamiento hay más probabilidades de un contagio o enfermedad, entonces se les dan antibióticos en dosis bajas toda su vida para prevenir enfermedades. El tercero es cuando, en algún caso si se da una enfermedad se le dan los antibióticos como tratamiento para erradicarla”, afirmó Karen Reyes, vocera de Colombia para la ONG internacional Sinergia Animal.
Añadió: “Con el uso extendido de estos antibióticos se genera una resistencia, esto que quiere decir, que las bacterias van volviéndose más fuertes y ya el tratamiento no es tan efectivo como lo sería si se hubiera administrado el antibiótico una sola vez, entonces esto es lo que se denomina una superbacteria”.
Por lo que la experta recomendó que se debe tener cuidado con los animales, ya que estas bacterias se transmiten por contaminación de suelos, el agua, el aire o nuestra comida a través del excremento animal y otros fluidos, siendo difíciles de erradicar.
"Un cambio de políticas es necesario para detener esta amenaza a la salud pública y es por eso que le pedimos a los gobiernos de los países latinos que prohíban el uso irresponsable de antibióticos en la industria ganadera”, concluyó Reyes.
La ONG Sinergia Animal invita a los ciudadanos a firmar su petición: change.org/pandemiascolombia.